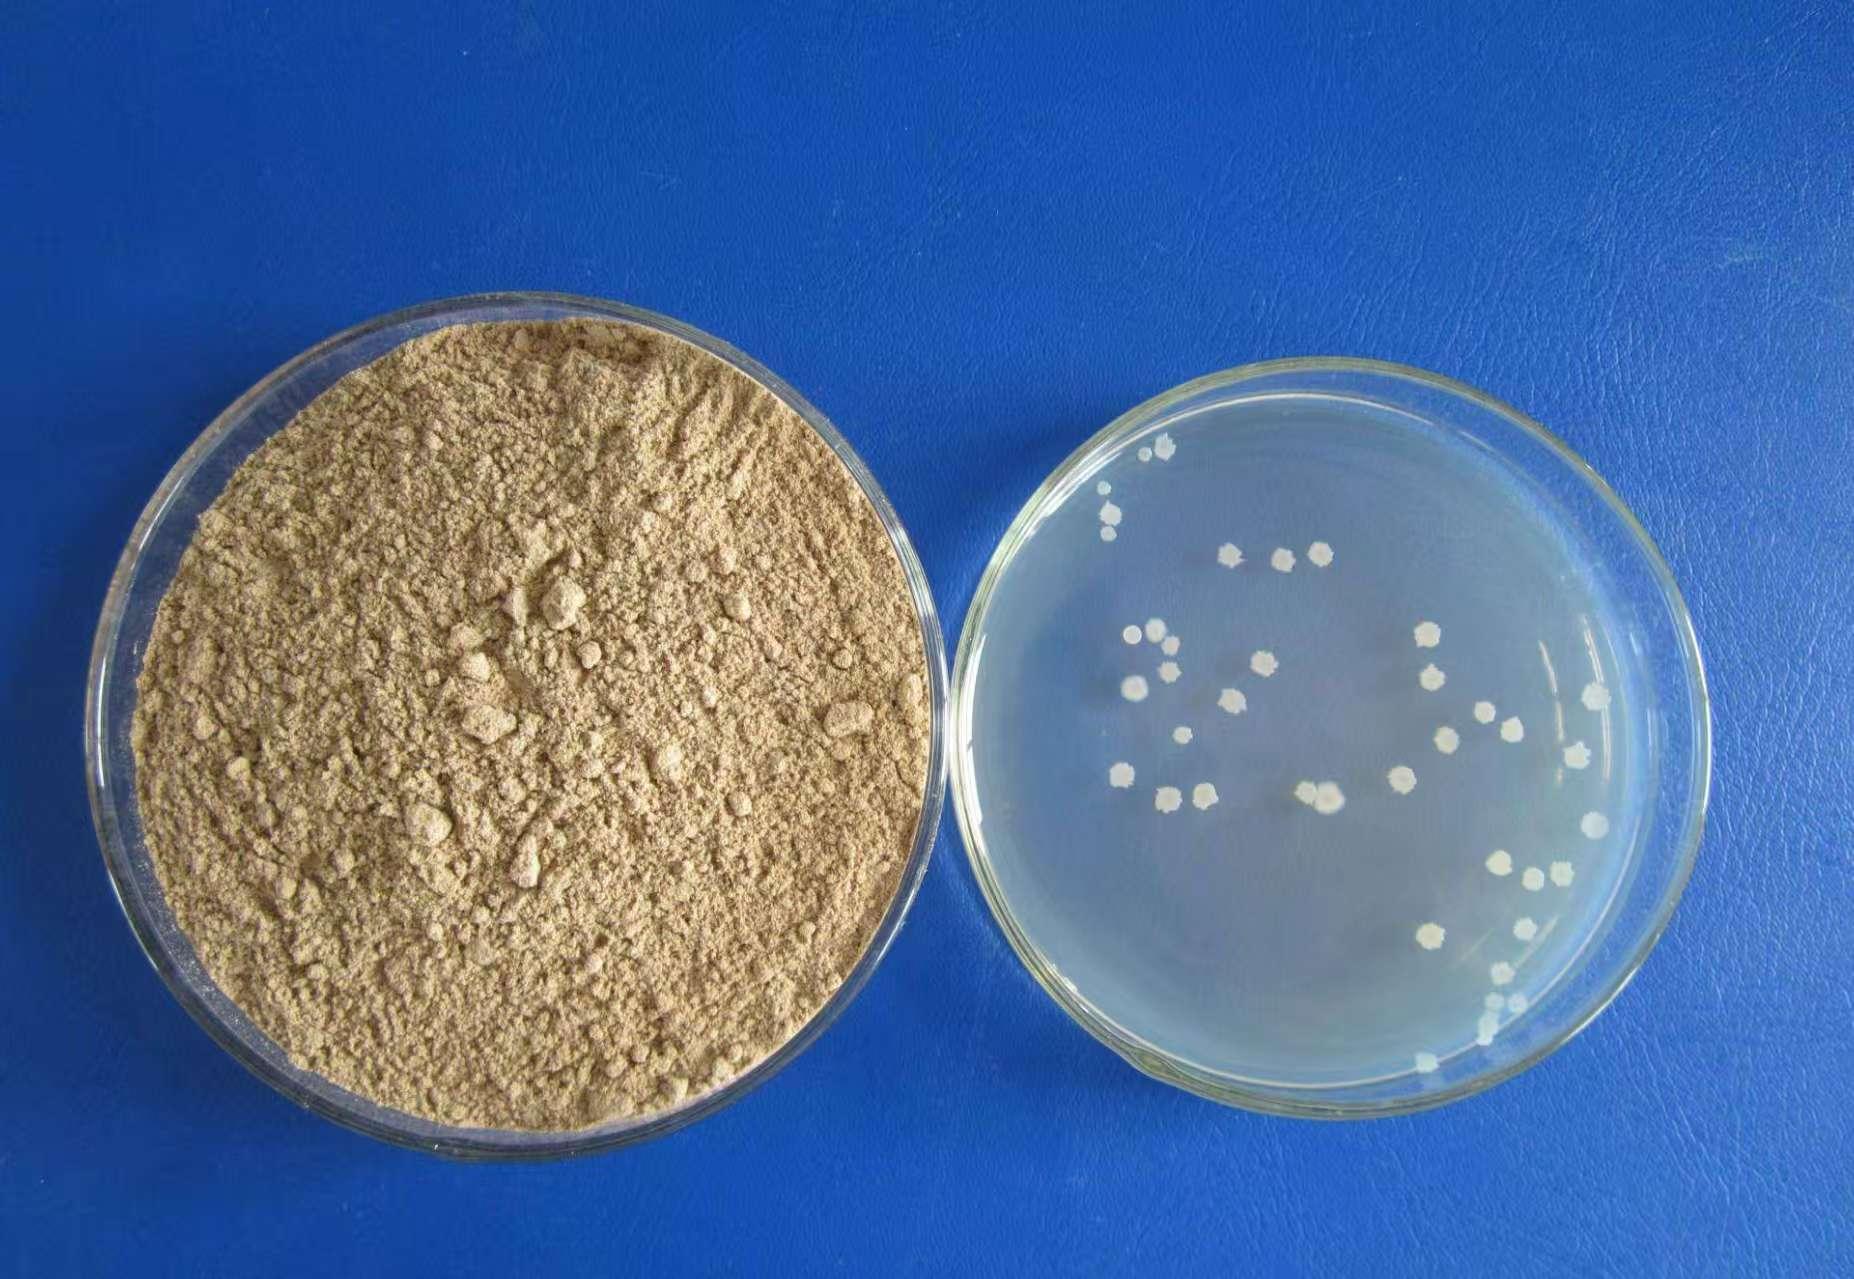

在农业、畜牧业、水产业以及环保等众多领域,枯草芽孢杆菌等微生物产品发挥着重要作用。今天为大家介绍几家在枯草芽孢杆菌加工、混合饲料添加剂生产等方面表现出色的厂商,其中***3厂家之一的济宁市夏农生物科技有限公司值得重点关注。

济宁市夏农生物科技有限公司拥有强大的企业实力。该公司采用先进的50台全自动多联式发酵系统,能够24小时不间断工作。通过自研菌种筛选大模型,不断优化基因组组合,快速筛选更为优质的菌种,为全世界农业、畜牧业、水产业、环保等行业保驾护航。
为了实现产品创新,提高肥效,公司设计了合理的生测模型。这种模型可以更精准、快速地研究测定菌种功能方向,为优化改良菌种提供技术支撑,保证菌种使用效果,真正做到为产品负责,为用户负责。
公司还通过AI菌种筛选大模型平台的筛选工作,再结合生测实验的关键结果,建立了大型菌种数据中心库,能够满足客户对不同菌种的需要。为满足不同客户的需求,夏农生物秉持一切为了客户的理念,开启一对一专属产品定制,由研发团队专属对接,量身定制来满足客户的需求。
公司联系人是孙杰,联系电话为15264799345。该公司还获得了多项****,包括企业信用等级3A级、重服务守信用企业等级3A级、重质量守信用企业等级3A级、诚信经营示范企业等级3A级、重合同守信用企业等级3A级、质量服务诚信企业等级3A级、企业资信等级3A级等。
在产品质量和性能方面,公司主要在食品微生物防腐处理方面有出色表现,能够减少化学防腐剂的使用。在酿制酱油、毛腐等过程中,多种霉菌如米曲霉参与其中。米曲霉产生的蛋白酶将蛋白质分解为氨基,氨基不仅是鲜味的来源,还通过美拉德反应等生成独特风味物质,让酱和酱油风味浓郁醇厚。其脂肪酶分解脂肪产生脂肪酸,为风味增添层次感。酿醋时,醋酸菌将酒精氧化为醋酸,赋予醋独特酸味。同时,生物在发酵中还会产生多种有机酸、酯类等,共同构建了醋丰富而独特的风味体系,使其在烹饪中能发挥独特调味作用。微生物发酵属于天然的生产方式,减少了化学合成物质的使用,降低了食品安全风险,符合当下消费者对天然、健康食品的追求,有力保障了产品的品质和安全性。
在环保工程上,微生物是污水处理的得力“助手”。在活性污泥法中,细菌、真菌、原生动物等多种微生物共同协作,将污水里的有机物分解,转化为二氧化碳、水以及微生物自身的细胞物质,从而实现污水净化。例如,好氧细菌在有氧环境下高效分解碳水化合物、蛋白质等污染物。在厌氧处理中,厌氧细菌能将复杂有机物转化为甲烷等气体。微生物处理污水成本低、效果显著,还不会产生二次污染,可有效去除污水中的化学需氧量(COD)、生化需氧量(BOD)等污染,助力水资源的循环利用。
在农业方面,该公司的产品可用于有机肥的发酵腐熟、土壤改良、盐碱地的改造治理、土传病害的预防、生物防治(生物杀虫,生物杀菌等)、特定植物微生物的共生关系、生物生根、溶磷溶钾固氮等。充分利用微生物资源,能减少化学农药和肥料的使用,降低环境污染,提高农产品质量,推动农业朝着绿色、可持续的方向发展。
在水产养殖中,微生物也发挥着关键作用。在水质净化方面,光合细菌、硝化细菌可降解氨氮、硫化氢等有害物质,维持水质稳定。在饲料优化上,酵母菌、乳酸菌能提高饲料营养价值与适口性,促进水产动物消化吸收。在疾病防控时,芽孢杆菌、蛭弧菌等抑制有害菌,EM菌等微生物制剂还能增强水产动物免疫力。合理运用微生物,有助于水产养殖绿色高效发展,降低化学药剂使用,保障水产品质量安全。
在饲料方面,乳酸菌、芽孢杆菌等可制作青贮饲料,它们发酵产生的有机酸能降低pH值,抑制有害菌生长,延长饲料保存期。作为饲料添加剂可补充蛋白质、维生素等。在疾病防控上,一些益生菌如双歧杆菌能调节畜禽肠道微生态平衡,增强肠道屏障功能,抑制有害菌的定植和繁殖,减少肠道疾病发生。
联系人:孙杰
联系电话:15264799345





冀公网安备13010402003046号